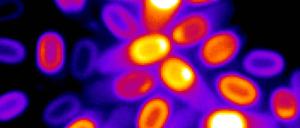

Was Wale fressen, lässt sich an gestorbenen Tieren gut untersuchen. Auf die Frage, wie viel sie fressen, liefern Laborversuche nun eine neue Antwort.

Was Wale fressen, lässt sich an gestorbenen Tieren gut untersuchen. Auf die Frage, wie viel sie fressen, liefern Laborversuche nun eine neue Antwort.

Meeresschutzgebiete kommen der Fischerei zugute, auch wenn Fanggebiete kleiner werden. Erfahrungen vor Hawaii lassen sich bislang aber nicht auf deutsche Gewässer übertragen.
Bacillus-Sporen erwachen bei günstigen Bedingungen aus ihrer Starre. Forscher haben jetzt herausgefunden, wie sie das machen.

Vor 440 Millionen Jahren entwickelte sich in Fischen nicht nur der Kiefer, mit dem heute die meisten Wirbeltiere zubeißen, sondern auch Vorläufer der Flossenpaare, aus denen später Gliedmaße wurden.

Ein enges Geflecht aus Blutgefäßen schützt das Gehirn von Walen beim Tauchen vor Druckschäden. Damit können die Meeressäuger Energieverluste minimieren.

Nach vorne gerichtete Augen und Greifhände. Die Evolution von Primaten wie uns könnte maßgeblich von neuen Nahrungsquellen vorangetrieben worden sein.

Warum der Eingriff notwendig wurde, bleibt offen. Aber ein Skelettfund belegt, dass die Operation vor über 30.000 Jahren erfolgreich verlief.

Für künftige Marsmissionen und ihre Rückkehr zur Erde sind große Mengen Sauerstoff notwendig. Wie er beschafft werden könnte, zeigt ein Experiment vor Ort.

Erst wird er wegen seiner Felle gejagt, dann von Amerikanischen Verwandten vertrieben. Der Europäische Nerz ist vom Aussterben bedroht. Helfen kann ihm nur noch der Mensch

Eine neue Analyse eines alten Fossilienfundes zeigt, ab wann die Vorfahren des modernen Menschen die Hände meist frei hatten.

Für die wachsende Weltbevölkerung müssen mehr Nahrungsmittel produziert werden. Dabei könnte helfen, den Sonnenschutz von Pflanzen zu verändern.

Ein fossiler Oberschenkelknochen zeigt, dass Riesenschildkröten deutlich länger in Europa überlebten als angenommen.

Das Erdklima wandelte sich schon vor der aktuellen Erwärmung. Ein neues Projekt soll den bislang tiefsten Einblick in die bewegte Geschichte liefern.

Der biologische Artbegriff als exklusive Reproduktionsgemeinschaft ist zu eng gefasst, zumindest für Paviane und wahrscheinlich auch den Menschen.

Salzwiesen schützen Siedlungen und Ackerland vor Fluten. Mit dem Klimawandel drohen sie aber unterzugehen.

Wie die Schildkröte in Mitteleuropa bisher überlebt hat und was ihr heute das Leben schwer macht. Ausgerechnet der Wolf könnte ihr zur Hilfe kommen.
Eine neue Studie kommt zu dem Ergebnis, dass der Klimawandel die Lebensräume der Wale im Nordpolarmeer verkleinern wird. Durch schmelzendes Eis entstehen weitere Probleme.

Der Klimawandel auf der Erde macht Wäldern zunehmend zu schaffen. Doch es gibt auch Orte, an denen das Pflanzenwachstum bislang eher profitiert.

Steinwerkzeuge gelten als frühe Zeugnisse menschlicher Kultur. Doch sie könnten dank einer anderen Fähigkeit entstanden sein als der, Wissen weiterzugeben.

Die Inseln Mikronesiens wurden in mehreren Wellen besiedelt. Zwischen den Inseln wanderten zunächst vor allem die Männer.

Schildkröten, Brückenechsen und einige Salamander altern erheblich langsamer als Menschen und andere Säugetiere. Untersterblich sind sie allerdings nicht.

Sie war eine der verheerendsten Pandemien des 14. Jahrhunderts. Eine DNA-Analyse zeigt, wo die Pest ihren Anfang nahm.

RNA-Viren im Meer beeinflussen das Algenwachstum und das Klima – und damit auch den Speiseplan von Raubfischen.

Jagd, Landwirtschaft, Verstädterung und Entwaldung: Eine globale Erhebung zeigt wie bedroht Reptilien sind und wie sie besser geschützt werden können.
öffnet in neuem Tab oder Fenster